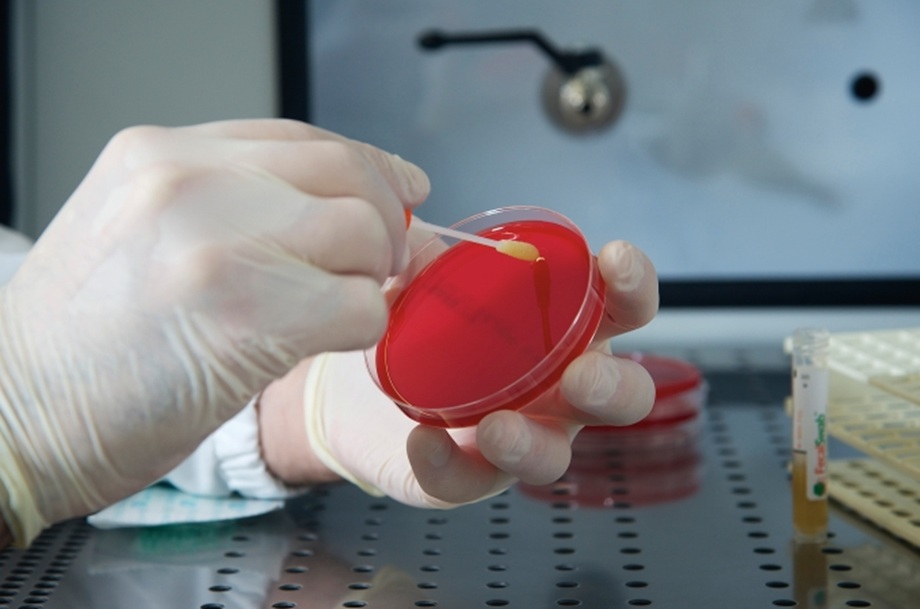

Comunicado. Becton Dickinson (BD) y Envetec Sustainable Technologies anunciaron la finalización exitosa de un estudio de factibilidad conjunto para probar la capacidad de reciclar placas de petri de poliestireno en materia prima de fabricación nueva y de alta calidad.
Los resultados del estudio piloto sugieren que polímeros similares de alta calidad, como el poliestireno, el poliéster (PET), el polipropileno y el polietileno, podrían reutilizarse en la cadena de suministro de fabricación tras ser desinfectados y procesados de forma segura. Estos polímeros se utilizan ampliamente en dispositivos médicos, como los fabricados por BD.
La tecnología GENERATIONS de Envetec convierte los residuos regulados en escamas de polímero reciclables mediante un proceso validado de desinfección química de bajo consumo energético. En el piloto de BD, los medios de cultivo en placa preparados con BD BBL™ no utilizados se procesaron como material postindustrial. Las placas y su contenido se trituraron, separaron, desinfectaron químicamente y transformaron en escamas de polímero limpias y recicladas. Estas escamas se extruyeron en pellets de poliestireno y se moldearon en nuevos prototipos de placas de Petri. Las pruebas de propiedades del material y la viabilidad del moldeo se completaron con éxito.
“Este proyecto piloto marca el primer paso de un esfuerzo más amplio para demostrar la viabilidad de recuperar y reciclar diversos tipos de productos plásticos en las cadenas de suministro de la salud”. Al crear una prueba de concepto para una vía que permite tratar de forma segura los plásticos regulados y devolverlos a un uso productivo, abrimos la puerta a soluciones sostenibles que pueden ayudar a la industria a evitar los vertederos y a mantener la circulación de materiales valiosos”, declaró Malcolm Bell, director ejecutivo de Envetec Sustainable Technologies.
Envetec y BD ven oportunidades claras para ampliar el piloto, reducir la dependencia del plástico virgen y mantener polímeros de alto valor en circulación.
"Los dispositivos desechables fabricados con plásticos de alta calidad desempeñan un papel fundamental en la atención médica moderna gracias a su seguridad, facilidad de uso y escalabilidad, pero reconocemos el impacto a largo plazo que estos materiales pueden tener en el medio ambiente. Este proyecto piloto, llevado a cabo por el Instituto de Tecnologías Médicas Sostenibles de BD, representa un paso importante hacia la implementación de soluciones de economía circular para otros consumibles sanitarios de gran volumen fabricados con plásticos de uso común, como tubos de extracción de sangre, jeringas y envases", afirmó Nikos Pavlidis, presidente mundial de Soluciones de Diagnóstico de BD.
La tecnología GENERATIONS de Envetec se está implementando actualmente en instalaciones biofarmacéuticas y de ciencias de la vida, hospitales y sectores de alimentos y bebidas en Estados Unidos y Europa. Esta tecnología procesa residuos médicos y biopeligrosos regulados, transformándolos en escamas de polímero limpias, aptas para el reciclaje.
Hoy también publicamos las siguientes notas y más...
MSD anula negociaciones para adquirir a Revolution Medicines